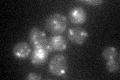
YDR484W
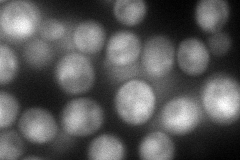
YDR484W
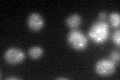
YDR484W

View description
Component of the GARP (Golgi-associated retrograde protein) complex, Vps51p-Vps52p-Vps53p-Vps54p, which is required for the recycling of proteins from endosomes to the late Golgi; involved in localization of actin and chitin
Localization:
Intensity:
Fold change:
Significance:
-
C’ GFP library in SD
punctate23.28 -
N' NOP1pr-GFP in SD

cytosol,punctate68.9156 -
N' TEF2pr-mCherry in SD
cytosol,punctate,bud103.167 -
N' NATIVEpr-GFP in SD

punctate26.6974 -
N' TEF2pr-VC and Cyto-VN in SD

cytosol,punctate37.4571 -
C’ GFP library in SD+DTT
punctate24.061.03No -
C’ GFP library in SD+H2O2

punctate23.491No -
C’ GFP library in Starvation Media

punctate26.31.12No -
C’ GFP library on the background of Pup2-DaMP

punctate -
C’ GFP library on the background of CCT mutant

punctate17.9430.770471No
